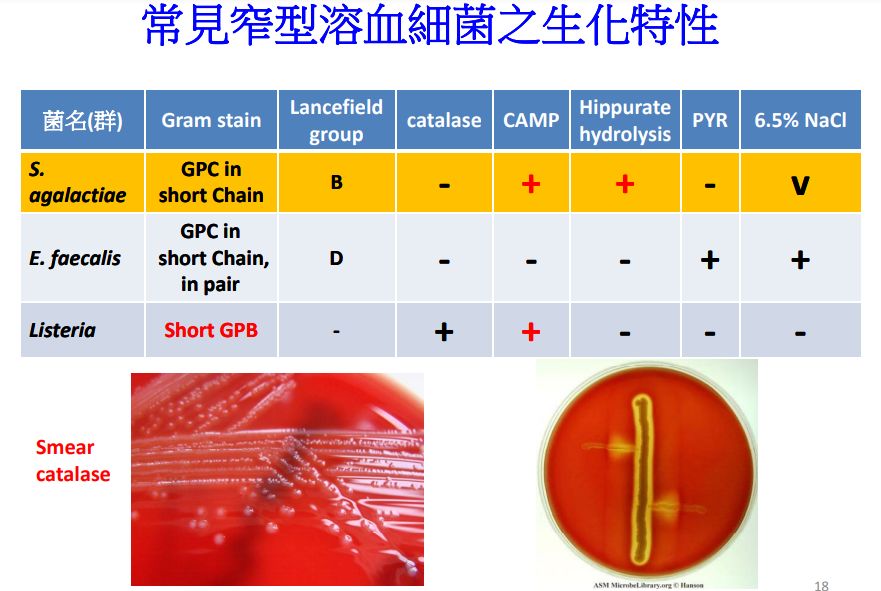
60d1bdf14310a.jpg

3.下列何者不適合用於區別Listeria monocytogenes與Streptococcus agalactiae?
(A)BAP上之菌落特徵
(B)catalase test
(C)esculin hydrolysis
(D)室溫motility test
答案:登入後查看
統計: A(1537), B(456), C(478), D(253), E(0) #1840371
統計: A(1537), B(456), C(478), D(253), E(0) #1840371
詳解 (共 10 筆)
#4826287
0
3